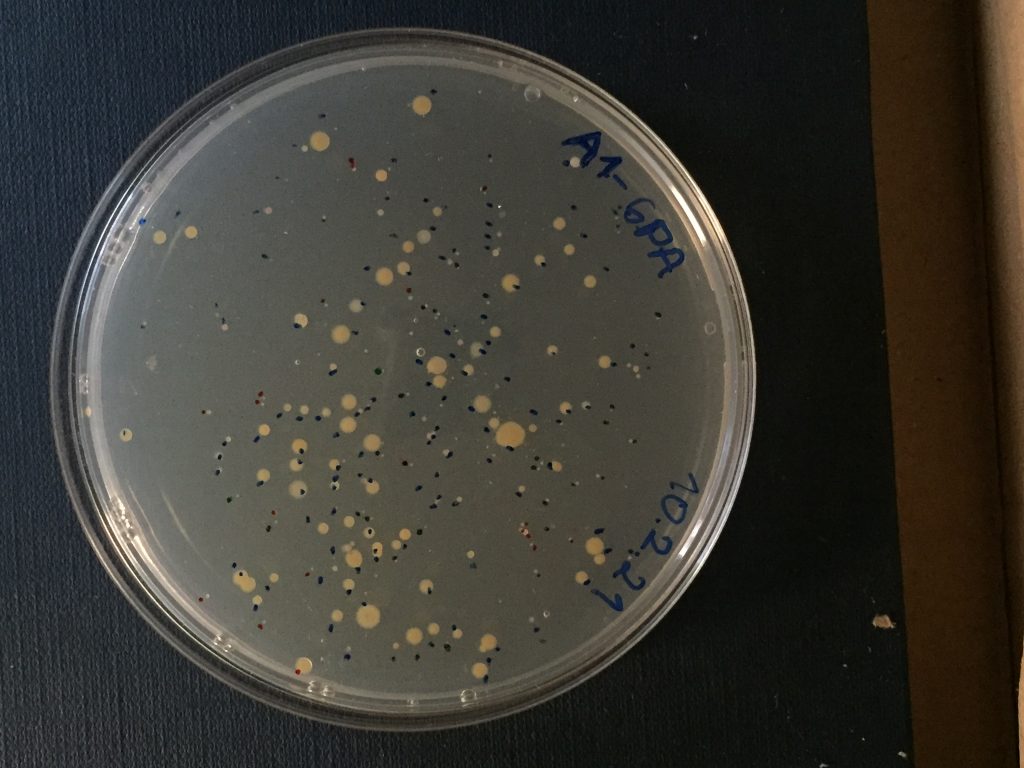

Foi numa bela quinta-feira soalheira que uma equipa do Departamento de Novos Biopesticidas, envolvida no projeto XfSTOP, se deslocou à Herdade do Álamo de Cima, pertencente à Fundação Eugénio de Almeida, perto de Évora, e regressou com um automóvel repleto de ramos de oliveira e amendoeira.
E não foi, naturalmente, pelo prazer de podar árvores. O objetivo foi a recolha de amostras de duas culturas muito importantes para a economia agrícola local, e que são alvos da nefasta bactéria Xylella fastidiosa, para a qual o InnovPlantProtect pretende desenvolver um novo biopesticida.
Os investigadores recolheram amostras de quatro variedades de oliveira – Cobrançosa, Arbequina, Galega e Picual – e outras quatro de amendoeira – Solena, Guara, Belona e Avijor. Este trabalho vai permitir isolar endófitos bacterianos comuns à oliveira e à amendoeira. No dia seguinte, sexta-feira, a equipa processou as amostras.
Começaram por cortar ramos com cerca de 15-20 cm, retirar a casca, desinfetar o exterior do ramo para eliminar os microrganismos epifíticos e macerar os vasos do xilema com uma solução tampão. Essa solução é depois filtrada em sacos específicos, diluída, plaqueada em meio de cultura e colocada numa incubadora a 30 ºC durante cerca de 15 dias. Ao longo desse período, monitoriza-se o aparecimento de colónias.

Do amendoal… para o laboratório.























Discussão sobre este post